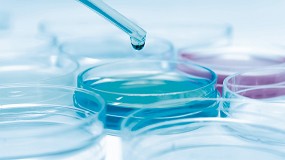
Cmo Condair RS revolucion el control higromtrico en la empresa Almirall en Barcelona

Condair Humidificación, S.A. - Datos de contacto
NOTA: Aunque hemos hecho esfuerzos razonables para comprobar la corrección de la ubicación de la empresa/entidad, no podemos garantizarla al 100%
Productos
Catálogos
Noticias
Industria Farmacéutica y Cosmética
Cómo Condair RS revolucionó el control higrométrico en la empresa Almirall en Barcelona19 mayo, 2025
Industria Farmacéutica y Cosmética
Garantizar la excelencia de los procesos sensibles gracias a la humidificación y el control de la humedad en la producción farmacéutica28 agosto, 2023
Climatización e instalaciones
Los beneficios de la humidificación en la prevención de arrugas y roturas en el papel29 mayo, 2023